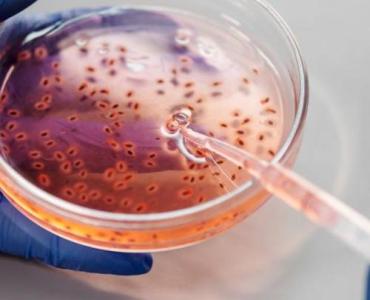
Postaw kropkę nad i w diagnostyce boreliozy: jak test Western blot potwierdza wyniki i przyspiesza drogę do zdrowia

Twoja skóra jest szorstka, matowa i pełna nierówności? Poznaj sprawdzone, bezpieczne i skuteczne sposoby, dzięki którym zbudujesz rutynę pielęgnacyjną wygładzającą, wzmocnisz barierę skórną i odzyskasz promienny blask. Oto kompletny przewodnik od A do Z – od podstaw, przez składniki aktywne,…
Skóra piecze, swędzi i buntuje się pod maseczką, kaskiem czy ramiączkiem stanika? To może być trądzik mechaniczny – wysypka i wypryski wywołane tarciem, naciskiem, potem i ciepłem. Poznaj skuteczną, łagodną i sprytną rutynę, która zmniejsza podrażnienie, zapobiega kolejnym zmianom i…
Sucha cera nie musi oznaczać ściągnięcia i szorstkości. W 15 minut, z pomocą składników z kuchni, możesz przywrócić skórze miękkość, blask i komfort. Poznaj prostą, skuteczną maskę bananowo‑jogurtową, która intensywnie nawilża, koi i wspiera barierę hydrolipidową – bez skomplikowanych rytuałów…
Gładka, sprężysta i odporna skóra zaczyna się od mocnej bariery hydrolipidowej i „cementu” międzykomórkowego. Ten przewodnik pokazuje krok po kroku, jak przywrócić spójność lipidów w warstwie rogowej, ograniczyć TEWL, wyciszyć podrażnienia i zbudować pielęgnację, która działa – bez nadmiaru skomplikowanych…
W świecie pielęgnacji cery wrażliwej niewiele połączeń działa tak harmonijnie, jak bakuchiol i wąkrota azjatycka. Ten duet jednocześnie odmładza i koi, wzmacniając barierę hydrolipidową bez podrażnień typowych dla intensywnych kuracji. Oto przewodnik, który pomoże Ci zrozumieć, dlaczego serum z bakuchiolem…
Masz fale, loki lub sprężynki i chcesz, by wyglądały zjawiskowo każdego dnia? Ten przewodnik przeprowadzi Cię od definicji „curly” po kompletny plan stylizacji – krok po kroku, na różne typy skrętu, porowatości i warunki pogodowe. Dowiesz się, jak dobrać produkty,…
Hydrolaty to delikatne wody kwiatowe i roślinne powstające w trakcie destylacji parą, które działają jak naturalne toniki. Przywracają prawidłowe pH, koją, nawilżają i wzmacniają barierę hydrolipidową, a przy tym są lekkie i wielozadaniowe. Poznaj, jak wybierać, łączyć i stosować je…
Zastanawiasz się, jak bezpiecznie i skutecznie pozbyć się nieudanego, wykonanego „po znajomości” tatuażu? Ten obszerny przewodnik prowadzi krok po kroku przez nowoczesne metody laserowe, od konsultacji i planowania serii zabiegów, przez samą procedurę, aż po pielęgnację i profilaktykę powikłań. Dowiesz…
Ciemniejsze pachy najczęściej wynikają z tarcia, podrażnień po depilacji i drobnych stanów zapalnych. W tym przewodniku pokazujemy, jak bezpiecznie i skutecznie rozjaśnić skórę pod pachami naturalnymi metodami: od delikatnych peelingów enzymatycznych i masek z aloesu, po codzienne nawyki, które hamują…
Ciemny blond to idealna baza dla ombre, które potrafi optycznie rozświetlić cerę i dodać włosom wielowymiarowości bez efektu sztucznej peruki. W tym przewodniku znajdziesz praktyczne wskazówki krok po kroku, jak robić ombre włosy ciemne blond w domu lub zaplanować usługę…